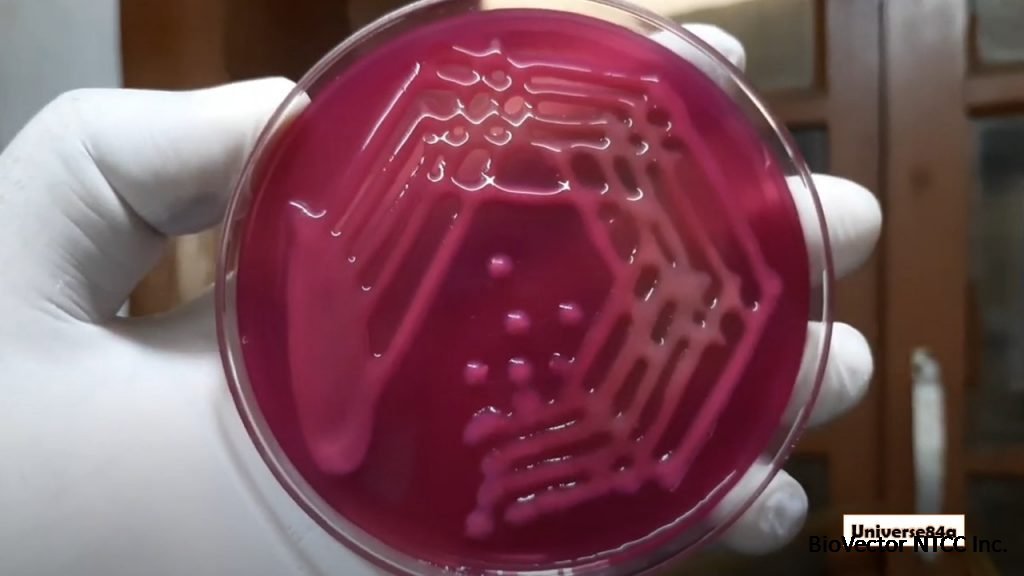
K pneumoniae:Introduction, Classification, Pathogenicity, Laboratory Diagnosis and Treatment

NBRC 13277 Klebsiella pneumoniae strain克雷伯氏肺炎菌株 BioVector NTCC质粒载体菌种细胞基因保藏中心
- 价 格:¥59865
- 货 号:NBRC 13277 Klebsiella pneumoniae
- 产 地:北京
- BioVector NTCC典型培养物保藏中心
- 联系人:Dr.Xu, Biovector NTCC Inc.
电话:400-800-2947 工作QQ:1843439339 (微信同号)
邮件:Biovector@163.com
手机:18901268599
地址:北京
- 已注册
NBRC 13277 Klebsiella pneumoniae strain克雷伯氏肺炎菌株
Synonymous Name Klebsiella pneumoniae subsp. pneumoniae
Cat# BioVector-13277
Teleomorph
Anamorph
Other Culture Collection No. ATCC 4352=CIP 104216=KCTC 2690=NCIB 10341
Other No. WDCM 00192
Herberium No.
Shipping as Glass ampoule (L-dried)
Type Strain
Biosafety Level L2
Restriction
Conditions of utilization
Plant Quarantine No.
Animal Quarantine No.
Source of Isolation Cow's milk
Locality of Source
Country/region of Origin
Accepted Date 1971/06/04
Isolated Year
Deposited Year
History IFO 13277 <- ATCC 4352 <- E.C. Robertson
Comment
Growth Condition
Rehydration Fluid 702
Medium 802
Cultivation Temp. 30 C
Image:
Supplier来源:BioVector NTCC Inc.
TEL电话:400-800-2947
Website网址: http://www.biovector.net
- 公告/新闻




